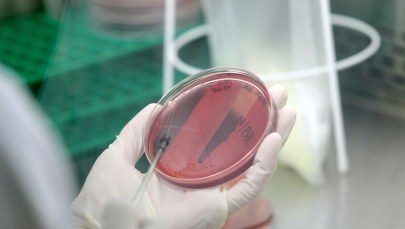
Bakterie coli w wodociągu w Drezdenku

Piętnaście tysięcy ludzi w lubuskim Drezdenku i okolicznych wsiach nie może pić wody z kranów, ani się w niej myć, bo są w niej bakterie coli. Od 9 rano władze miasta podstawiają beczkowozy i rozdają wodę butelkowaną.
W samym Drezdenku woda czeka na parkingu na osiedlu Mickiewicza, przy markecie przy ulicy I Brygady, na Placu Wileńskim i na parkingu przy Zespole Szkół im. H. Sienkiewicza na ulicy Portowej. Kolejna dostawa popołudniu - w tych samych miejscach beczkowozy staną o siedemnastej.
We wsiach, gdzie wodę dostarcza ta sama firma wodociągowa z Drezdenka, miejsca i godziny dostawy czystej wody są ustalane z sołtysami. Dotyczy to miejscowości Klesno, Kosin, Niegosław, Lipno, Osów, Trzebicz Nowy, Trzebicz, Trzebicz Młyn, Gościm i Bagniew.
Drezdenko i okoliczne wsie nie mogą korzystać z wody w pełnym zakresie od wczoraj. Wtedy sanepid ogłosił obecność bakterii coli, co oznacza, że obecnie można tylko używać wody z wodociągów do spłukiwania sanitariatów.